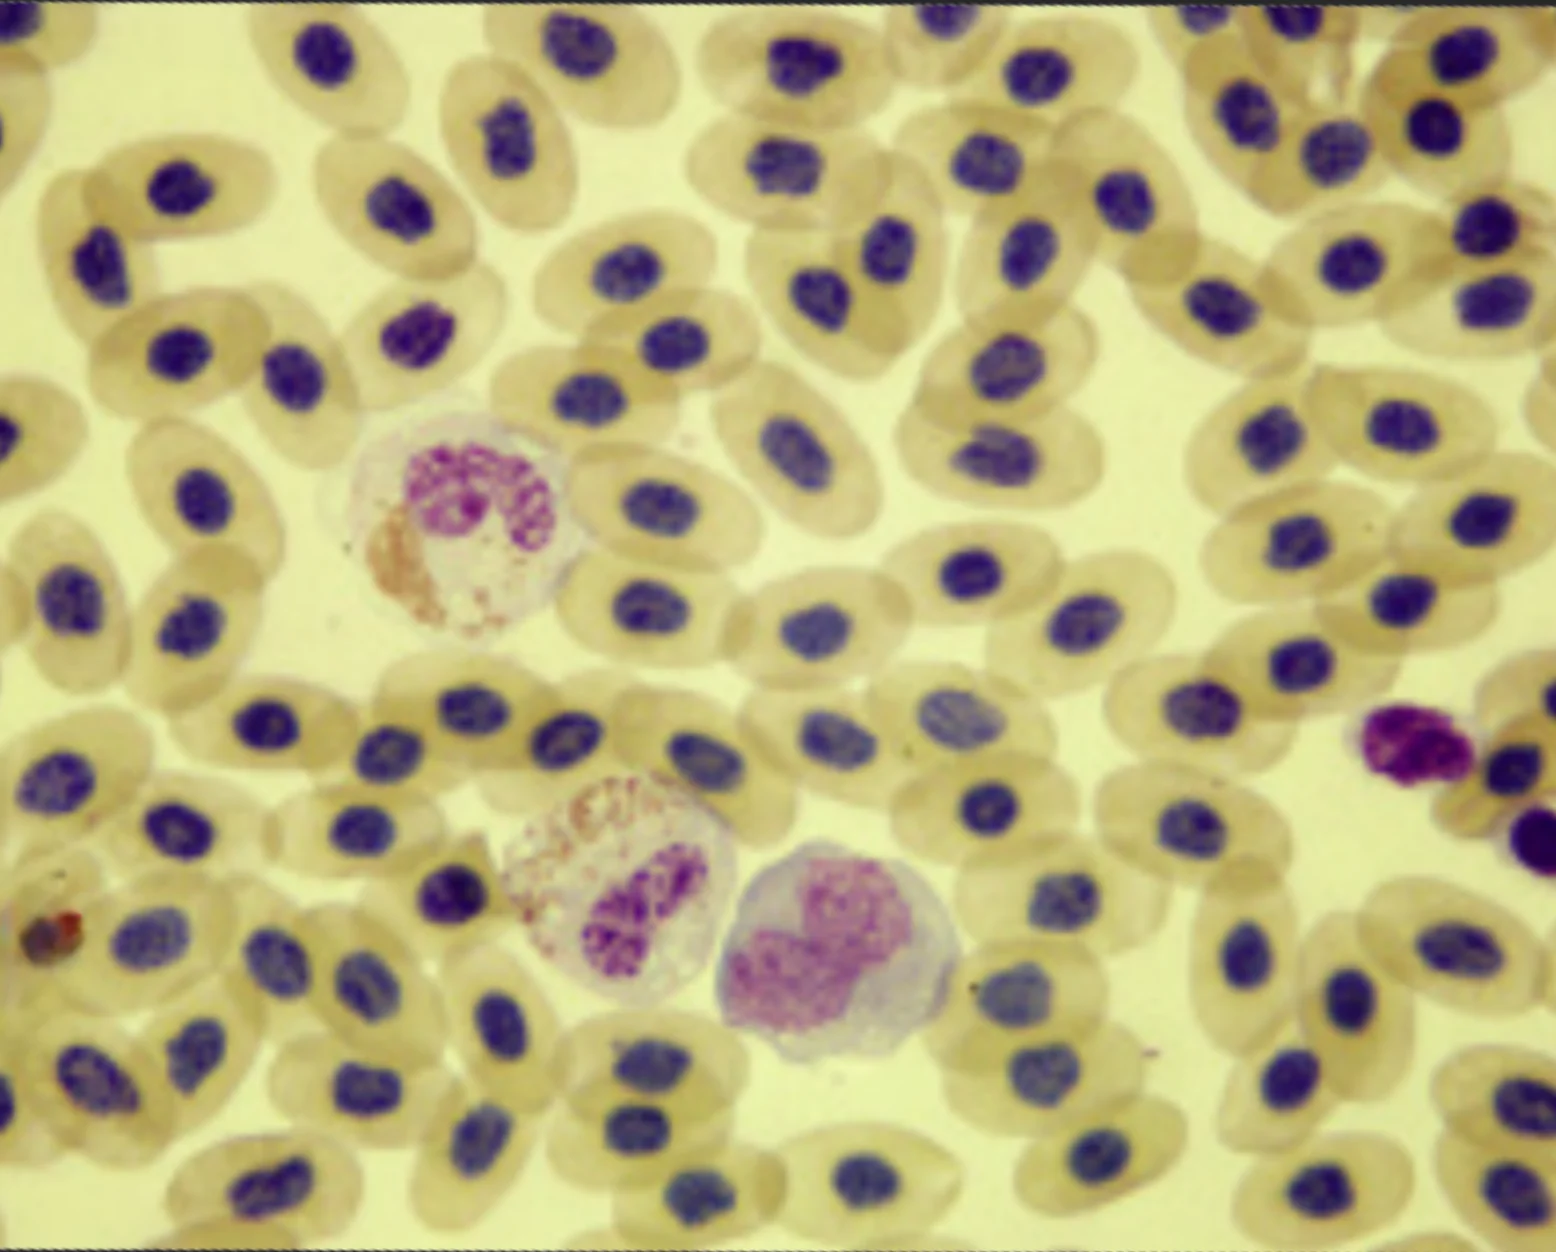
Featured Image

Evaluating Blood Films in Reptiles
An 8.5-year-old female green iguana (Iguana iguana) presented with a 5-day history of constipation.
History. The owner reported that the iguana had been constipated in the past and would respond to mineral oil treatments provided both orally and via the cloaca. There was no response, however, this time.
The iguana was fed an appropriate diet, but she had been partially anorectic during the past week. A homemade cage provided an adequate captive environment for a large tropical reptile. Except for periodic constipation, the iguana had not been ill in the past.
Physical Examination. The 2.58-kg iguana exhibited moderate distention of the coelomic cavity. She was active and responsive, with a normal respiratoryate. It was noted that only urine was present in her droppings.
Initial Diagnostics. Hemogram results are listed in the Table. Figures 1 through 3 show the hemic cytologic features from the blood film.
Additional Diagnostics. Whole-body radiography revealed a radiopaque coelomic cavity, with indiscernible coelomic organs. Serum biochemical profile showed a phosphorous concentration of 14.6 mg/dL (reference range, 4–6 mg/dL), a calcium concentration of 14.6 mg/dL (reference range, 8.8–14 mg/dL), and a total protein concentration of 8.4 g/dL (reference range, 5–7.8 g/dL).1 An aspirate of the coelomic cavity obtained using a 22-gauge needle revealed a thick yellow fluid (Figure 4).
Ask Yourself...
When should hemic cytology (examination of blood films) be performed?
What information can be obtained from microscopic examination of blood films?
When should a celiocentesis (aspiration of the coelomic cavity) be performed?
What are the basic classifications of coelomic effusions?
Table: Hemogram Results1
Blood film showing 4 toxic heterophils, 2 lymphocytes, and a thrombocyte (left margin) Wright’s–Giemsa stain; original magnification, 100×
Blood film showing 2 toxic heterophils, a monocyte, and a thrombocyte Wright’s-Giemsa stain; original magnification, 100×
Blood film showing a toxic heterophil and a basophil Wright’s–Giemsa stain; original magnification, 100×
Coelomic fluid showing numerous heterophils and macrophages that contain large cytoplasmic vacuoles. The appearance of the heavy background suggests lipid material, and a large basophilic amorphous object is visible Wright’s–Giemsa stain; original magnification, 50×
Diagnosis: Egg-Related Coelomitis
Q: When should hemic cytology (examination of blood films) be performed?
A: Examination of blood films is one of the most informative diagnostic procedures available to the practicing veterinarian. Hemic cytology is part of the complete blood cell count, and the results are reported as part of the hematologic findings.
Blood films should be evaluated whenever the results of the hemogram are in question—for example, when the number of leukocytes in the blood film appears to be different from the actual cell count reported. In this example, it was used to obtain relatively inexpensive data to help guide diagnosis and treatment.
It is always good practice to perform an in-house examination of the blood film of any exotic animal patient. By doing so, one can obtain a quick diagnosis and, in some cases, check results from reference laboratories that may or may not be proficient in exotic animal hematology.
Q: What information can be obtained from microscopic examination of blood films?
A: Microscopic examination of a stained blood film allows for a systematic evaluation of the 3 major cell types in blood: leukocytes, erythrocytes, and thrombocytes or platelets. Hemic cytology will provide information on not only the numbers but also the structure of the various blood cells in the sample.
In this case, the images suggest that the actual cell count was probably higher than what was reported, and the appearance of abnormal heterophil morphology provides evidence of severe inflammation or infection independent of the actual cell count.2
Q: When should a celiocentesis (aspiration of the coelomic cavity) be performed?
A: Aspiration of the coelomic cavity for cytologic evaluation should be performed whenever an increase in free fluid in the coelomic cavity is suspected. In this case, the iguana exhibited moderate distention of the coelomic cavity and the radiographs revealed a radiopaque appearance to the coelomic cavity that suggested the presence of fluid.
Q: What are the basic classifications of coelomic effusions?
A: Coelomic effusions can be classified according to their cellular and chemical properties as a transudate, modified transudate, exudate, hemorrhagic effusion, chylous effusion, or malignant effusion.
In these images, the inflammatory cells, heterophils, and macrophages are the predominate cells present and represent a mixed cell inflammation. The background material reveals numerous round vacuoles, indicating lipid material, and occasional large basophilic amorphous material. These features represent an egg-related coelomitis.3
The serum biochemical profile supported active folliculogenesis in this female iguana on the basis of the elevated calcium and total protein levels. The phosphorous level was also elevated, which is often seen in female iguanas undergoing active folliculogenesis. In such cases, the extra phosphorus is presumed to be providing additional binding sites for calcium transport; however, the hyperphosphatemia could also result from excessive dietary phosphorus, hypervitaminosis D3, and renal failure.